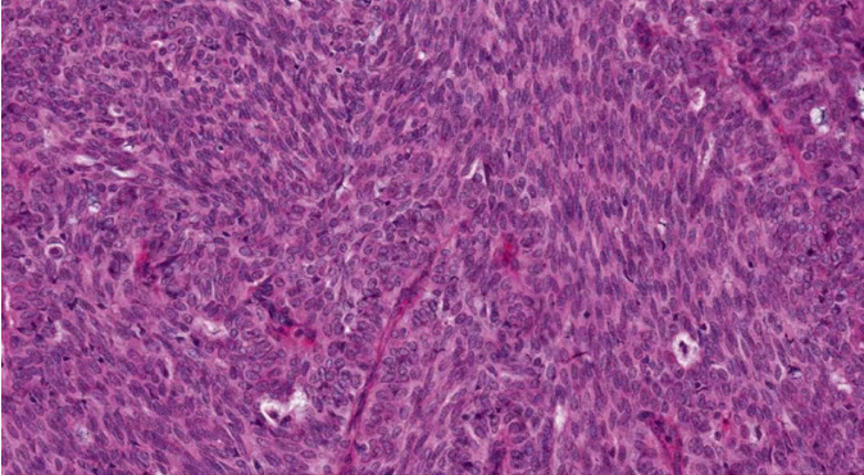
579_27.png

乳腺实性乳头状肿瘤诊断与鉴别诊断
患者,女,81岁,发现右乳肿物1月余,B超:右乳低回声结节(BI-RADS 4A)
右乳肿块:淡黄色组织一块约直径1.9cm,切面见直径1.6cm的灰白灰红色结节,界清,质中。








最终诊断:(右)乳腺实性乳头状癌,伴浸润,浸润成分为富于细胞的粘液癌。
——————————————————————————————————
患者,女,73岁,发现左乳肿物1月余,左乳头轻度内陷、固定,左乳外上象限乳晕处扪及质硬肿物,约3.0*2.5cm大小,类圆形,表面欠光滑,边界欠清晰,活动度欠佳,无牙痛,按压肿物后左乳头可见少许淡血性溢液
B超:左乳腺低回声包块(BI-RADS 4B)
乳腺钼靶:左乳正外侧乳头旁类圆形等密度肿块,BI-RADS 4B)
左乳肿物:灰黄色组织一块约5.4*4.1*3.9cm,切面见直径1.9cm的暗红灰白区域,质中,界不清。











最终诊断:浸润性实性乳头状癌,部分为粘液癌。
实性乳头状癌(原位或浸润)是一种以纤细血管纤维轴心和实性生长模式为特征的肿瘤,常有神经内分泌分化,生物学行为为惰性。
ICD-O编码
8509/2 原位实性乳头状癌
8509/3 浸润性实性乳头状癌
临床特征:好发于老年女性可发生于任何部位,最常发生于中央/乳晕下可以累及乳腺中央区大导管,形成单发的囊实性肿物,也可累及周围的中小导管,形成散在分布的、导管原位癌样的模式。
结构特点:轮廓清楚的实性结节纤细的血管轴心。
导管原位癌的分布模式

虽未充满整个管腔,但实性生长。

纤细的脉管轴心

DCIS样,界限清楚、多个、膨胀性结节状

纤细的血管轴心周围细胞呈栅栏状排列
SPF细胞形态
特征性细胞:形态多样,卵圆形,梭形,多边形,印戒样或浆细胞样胞浆嗜酸性颗粒状,单形性,核低至中级别,染色细腻,可见小核仁核分裂少见(<5/10HPF)肿瘤细胞可有细胞内、外粘液形态单一,呈圆/卵圆形,胞浆淡染、嗜酸性颗粒状嗜酸性颗粒状



胞浆嗜酸性颗粒状胞浆,浆细胞样外观
流水状排列

细胞内黏液,印戒样细胞

细胞内外粘液,可以在细胞与纤维轴心之间,也可在细胞与导管壁之间细胞外黏液
原位癌VS浸润癌
原位SPC:轮廓光滑的圆形结节结节周围无促结缔组织增生结节周围肌上皮可有可无

浸润癌两种浸润方式
1、浸润性实性乳头状癌:保留实性乳头状结构,体积大的团巢,轮廓不规则,间质促纤维反应,肌上皮缺失,原位SPC背景
2、实性乳头状癌伴浸润:轮廓圆滑的结节,伴有浸润性成分,包括粘液癌,NET,浸润性癌(NST)

SPC+富于细胞的黏液癌

浸润性SPC
免疫组化
ER弥漫强+,Her2-,ki67低表达
具有神经内分泌表达:CgA、Syn(约70%的比例,阳性细胞表达不等)
CK5/6、CKH-,可斑驳性的残留
肌上皮内-,导管周可-可+
AB-PAS示多少不等
SPC是从原位癌到浸润癌的连续的形态学谱系。
原位SPC的乳头轴心及导管周边的肌上皮可以存在,也可以不同程度减少。原位SPC可被视为导管原位癌的特殊亚型,因此,临床可以按导管原位癌处理。极端状态下,导管周边的肌上皮可以完全缺失,此时可被称为膨胀性或推挤性浸润,其形态与原位SPC高度相似。研究显示,膨胀性浸润的SPC通常不发生转移,因此仍可按导管原位癌处理。
当在原位SPC的背景上,部分原位SPC轮廓变得不规则,或呈地图、锯齿状,并出现促纤维反应,或浸润脂肪,可称为原位SPC伴浸润(毁损性浸润),这时需按浸润癌处理。
鉴别诊断:伴普通型导管增生的导管内乳头状瘤



LCIS


包裹性乳头状癌乳头多而纤细,大部分位于一囊性腔隙内,少数可呈排列紧密的多结节状低-中核级
ER弥漫强+,Her2无扩增
伴浸润:包膜外出现不规则肿瘤细胞巢

EPCⅡ型,缺乏经典SPC细胞学形态

EPC伴包膜外浸润

神经内分泌瘤(NET)
浸润性癌,形态学具备经典的低/中级别神经内分泌肿瘤的特点:实性巢状、小梁状、乳头状、岛状、腺泡状;细胞呈梭形、浆样;浆丰富,嗜酸性颗粒状,具有神经内分泌颗粒乳腺神经内分泌癌不具有SPC的乳头状结构及黏液分泌。
如果形态并非典型的神经内分泌肿瘤形态,但部分细胞表达神经内分泌标志物,则不应诊断为NET,而应诊断为伴有神经内分泌分化的浸润性癌




SPC预后
属于低度恶性肿瘤,临床行为相对惰性,手术切除是首选。在没有浸润情况下,SPC预后良好,无细胞外渗及浸润性患者极少转移。
总结:SPC是一大类从原位癌→伴膨胀性浸润→伴毁损性浸润的特殊类型乳腺癌。因此病理报告中仅写“实性乳头状癌”是不精确的,临床医生应让病理医生进一步明确是纯粹的原位癌,还是伴有浸润的SPC。
原位SPC可被视为导管原位癌的特殊亚型,可沿乳腺导管蔓延,因此无论其长在乳腺中央还是周边,均应参照相应部位的导管原位癌处理。
当病理诊断了SPC,但报告中的原位癌占比、核级别、免疫表型或T/N分期任何一条与SPC的惰性生物学行为相左时,临床医生应建议病理医生复阅切片,以排除呈实性乳头状生长的其它类型,特别是高级别的乳腺癌。从而避免低诊断及低治疗。

